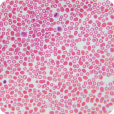

Lab -Tested Proof of Purity & Safety


























PCOS Support













































Daily formula that repairs the insulin resistance cortisol creates - the root cause behind your PCOS symptoms
Subscribe & SAVE 40%
One-time purchase
Buy 1
Save 13%$47.76
$47.76 / bottle

Extra Savings of 13% Off For Every Order

Out of Stock Protection

30 Day Money Back Guarantee

Pause or Cancel Anytime
BEST SELLER
Buy 2
Save 28%$79.06
$39.53 / bottle

Extra Savings of 28% For Every Order

Out of Stock Protection

30 Day Money Back Guarantee

Pause or Cancel Anytime
BEST VALUE
Buy 4
Save 40%$131.76
$32.94 / bottle

Extra Savings Of 40% For Every Order

30 Day Money Back Guarantee

Out of Stock Protection

Maximum Savings - Lowest Price Per Serving

Free Shipping To US/CAN/EU/AUS/NZ

Pause or Cancel Anytime
 30-day money back guarantee shop worry-free!
30-day money back guarantee shop worry-free!
Our team is available around the clock to answer any questions about your product.
If you’re not fully satisfied, we offer a hassle-free 100% money-back guarantee within the first 30 days.

“Great option for patients with insulin-driven PCOS-addressing the core issue behind fertility struggles, impossible weight loss, and hormonal imbalance”
Maria Morgan-Bathke, PhD, RD
PhD in Nutritional Sciences | Registered Dietitian
Lab Verified Results
Key Ingredients
Key Questions Answered
Unlike most brands, we use a validated ingredients and prove their purity with third-party testing.
Tap below to view our lab results.



Myo-Inositol & D-Chiro-Inositol (40:1)
Research-backed 40:1 ratio matches your ovaries' natural balance - protecting fertility and egg quality while improving insulin sensitivity

Berberine HCl (Pharmaceutical-Grade) – 500mg daily
Premium, highly bioavailable berberine reduces glucose production in the liver and improves how your cells use insulin
What's the difference between this and other inositol supplements?
Most inositol products use the wrong ratio or are severely underdosed. This usually happens because products use high D-Chiro ratios (1:1, 4:1) that can damage egg quality, or they contain only 500-1000mg when studies use 4,000mg daily. PCOS Support uses the research-backed 40:1 ratio at clinical doses, PLUS berberine to address the other half of insulin resistance most products ignore.
Will this work if I'm lean PCOS?
Yes. Insulin resistance affects 70-80% of women with PCOS regardless of weight -it can be driven by genetics, inflammation, or stress. PCOS Support targets the metabolic dysfunction whether you're overweight or at a normal BMI.
Can I take this if I'm already on metformin or birth control?
PCOS Support can generally be used alongside metformin (many women find they need less over time). However, you should NOT take it with birth control if you're trying to restore natural ovulation, as birth control suppresses ovulation by design. Always consult your doctor before combining supplements with prescription medications.
Why do I need berberine if I'm already taking inositol?
Inositol fixes how your cells respond to insulin (the signaling). Berberine lowers how much insulin your body produces in the first place (the demand). You need both to address insulin resistance completely -one without the other only does half the job.

Why Cortisol Makes Your PCOS Impossible to Manage




01.

Elevated Cortisol
Raises blood sugar and forces insulin production

02.

Insulin Resistance Develops
Your cells ignore insulin's signal

03.

Excess Androgens
Ovaries overproduce testosterone

04.

PCOS Symptoms Intensify
Weight gain, facial hair, irregular cycles, acne, fatigue
Evidence-Based Solutions for Your Most Challenging PCOS Symptoms
Evidence-Based Solutions for Your Most Challenging PCOS Symptoms
Fertility


Weight Management


Facial Hair & Skin


Mental Health & Energy


Evidence-Based Solutions for Your Most Challenging PCOS Symptoms
Evidence-Based Solutions for Your Most Challenging PCOS Symptoms
Fertility

PROBLEM
Your body isn't broken - your ovaries just need better insulin signalling.
Insulin resistance blocks ovulation, causing irregular or absent cycles and the terrifying fear that you'll never become a mother..


SOLUTION
PCOS Relief uses Myo/D-Chiro Inositol (40:1) to support ovarian insulin signaling and healthy follicle development, helping your body ovulate consistently and restore fertility.

Science-Backed Formula Built for Cortisol-Driven PCOS
Fertility-safe 40:1 inositol ratio and 99.9% pure berberine restoring the hormonal balance
Myo-Inositol & D-Chiro-Inositol (40:1)


Used to support:
Regular Cycles
Healthy Ovulation
Fertility
Reduced Facial Hair
NMN ensures your cells are provided with sufficient NAD+ levels, that rapidly decline with age. Think of it as "internal oxygen" that powers every cell.

Dihydroberberine (DHB) GlucoVantage®


Used to support:
Healthy Weight Management
Stable Energy
Reduced Cravings
Time fills your cells with biological debris that stifles energy. Urolithin A triggers a complete renovation: it clears out this toxic waste (mitophagy) and stimulates the growth of fresh, powerful mitochondria (biogenesis).
90% of Supplements Only Address Half the Problem


Clinically Proven To Improve The Symptoms
Clinically Proven To Improve The Symptoms
70%
Improvement cycle regularity
2.5x
Improvement in Ovulation Rates
50%
Reduction in Insulin Levels
45%
Reduction in free testosterone
7%
Decrease in Body Fat Percentage
60%
Reduced Emotional Eating / Cravings
70%
Improvement cycle regularity
2.5x
Improvement in Ovulation Rates
50%
Reduction in Insulin Levels
45%
Reduction in free testosterone
7%
Decrease in Body Fat Percentage
60%
Reduced Emotional Eating / Cravings
It helps.
Hear from real users
It helps.
Hear from real users
3,434+ Happy Customers


FERTILITY


“My period came back after being gone for 8 months. Three months later, I ovulated for the first time in over a year.”
Emily, 29
verified purchase

WEIGHT MANAGEMENT


"I ate 1200 calories daily and nothing budged for years. Within 12 weeks on PCOS Relief, I lost 15 pounds"
Jessica K., 44
verified purchase

FACIAL HAIR & SKIN


“The constant plucking was destroying my confidence. After 4 months, the hair growth slowed significantly and I finally feel like myself again"
Maria L, 31
verified purchase

MENTAL HEALTH & ENERGY


"Exhaustion and mood swings were making every day feel impossible. After 10 weeks, my energy stabilized and I'm not crashing every afternoon. I can actually plan my life and even enjoy socializing, again"
Rachel K, 25
verified purchase

FERTILITY


“My period came back after being gone for 8 months. Three months later, I ovulated for the first time in over a year.”
Emily, 29
verified purchase

WEIGHT MANAGEMENT


"I ate 1200 calories daily and nothing budged for years. Within 12 weeks on PCOS Relief, I lost 15 pounds"
Jessica K., 44
verified purchase

FACIAL HAIR & SKIN


“The constant plucking was destroying my confidence. After 4 months, the hair growth slowed significantly and I finally feel like myself again"
Maria L, 31
verified purchase

MENTAL HEALTH & ENERGY


"Exhaustion and mood swings were making every day feel impossible. After 10 weeks, my energy stabilized and I'm not crashing every afternoon. I can actually plan my life and even enjoy socializing, again"
Rachel K, 25
verified purchase

Frequently
asked questions
Can I take this if I'm already on metformin or birth control?

PCOS Support can generally be used alongside metformin (many women find they need less over time). However, you should NOT take it with birth control if you're trying to restore natural ovulation, as birth control suppresses ovulation by design. Always consult your doctor before combining supplements with prescription medications.
Will this work for lean PCOS?

Yes. Insulin resistance affects 70-80% of women with PCOS regardless of weight. Lean PCOS is often driven by genetics, inflammation, or stress - but insulin dysfunction is still typically present. PCOS Support addresses the metabolic root cause whether you're overweight or at a normal BMI.
What's the difference between this and other inositol supplements?

Most inositol products use the wrong ratio or are severely underdosed. This usually happens because products use high D-Chiro ratios (1:1, 4:1) that can damage egg quality, or they contain only 500-1000mg when studies use 4,000mg daily. PCOS Support uses the research-backed 40:1 ratio at clinical doses, PLUS berberine to address the other half of insulin resistance most products ignore.
Is this safe if I'm trying to conceive?

Absolutely. The 40:1 inositol ratio is specifically designed to protect fertility and egg quality (unlike high D-Chiro formulas that can damage eggs). Both inositol and berberine have been studied in women trying to conceive and are considered safe. Many women use PCOS Support to restore ovulation naturally before attempting pregnancy.
Why do I need berberine if I'm already taking inositol?

Inositol fixes how your cells respond to insulin (the signaling). Berberine lowers how much insulin your body produces in the first place (the demand). You need both to address insulin resistance completely -one without the other only does half the job.
Are there any side effects?

PCOS Support is generally well-tolerated. Some women experience mild digestive changes (bloating, soft stools) in the first week as their body adjusts to berberine -this typically resolves quickly. Unlike metformin, severe GI side effects are rare. Take with food to minimize any stomach sensitivity.
Will this work if I'm lean PCOS?

Yes. Insulin resistance affects 70-80% of women with PCOS regardless of weight. Lean PCOS is often driven by genetics, inflammation, or stress - but insulin dysfunction is still typically present. PCOS Support addresses the metabolic root cause whether you're overweight or at a normal BMI.
What is your return policy?

Our team is available around the clock to answer any questions about your product.
If you’re not fully satisfied, we offer a hassle-free 100% money-back guarantee within the first 30 days.

























